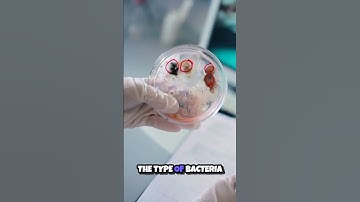
Unveiling the Microscopic World  Bacterial Colonies Explained 🔬
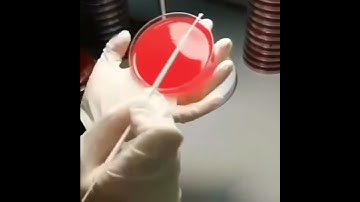
How do you Streak Bacteria on Agar Petri plate || Blood Agar || Culture of Bacterial colonies
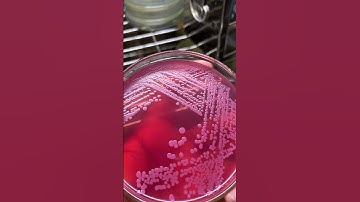
Colonies 🦠🧫 #microbiology #bacteria #fungus #science #biotechnology #agar #media #biology

⬇ DOWNLOAD NOW
Jika muncul iklan pop-up, tutup lalu klik tombol kembali
Download lagu Bacteria Movie - Agent based Modeling of three bacteria colonies secara gratis hanya untuk keperluan promosi. Dukung artis favorit kamu dengan membeli musik original di iTunes atau platform resmi lainnya.
 bacterial Colony under Microscope 🔬#contentcreator #lifeisbutadream #likesharesubscribe .....#shorts
bacterial Colony under Microscope 🔬#contentcreator #lifeisbutadream #likesharesubscribe .....#shorts Unlocking Microbiology The Secrets of Bacterial Colonies 🦠
Unlocking Microbiology The Secrets of Bacterial Colonies 🦠 ID Laboratory Videos: Isolating bacterial colonies
ID Laboratory Videos: Isolating bacterial colonies Unveiling the Microscopic World Bacterial Colonies Explained 🔬
Unveiling the Microscopic World Bacterial Colonies Explained 🔬 How do you Streak Bacteria on Agar Petri plate || Blood Agar || Culture of Bacterial colonies
How do you Streak Bacteria on Agar Petri plate || Blood Agar || Culture of Bacterial colonies Ant Colony Simulation: Agent Based Models
Ant Colony Simulation: Agent Based Models Colonies 🦠🧫 #microbiology #bacteria #fungus #science #biotechnology #agar #media #biology
Colonies 🦠🧫 #microbiology #bacteria #fungus #science #biotechnology #agar #media #biology Growth of Bacteria: Bacillus subtilis
Growth of Bacteria: Bacillus subtilis